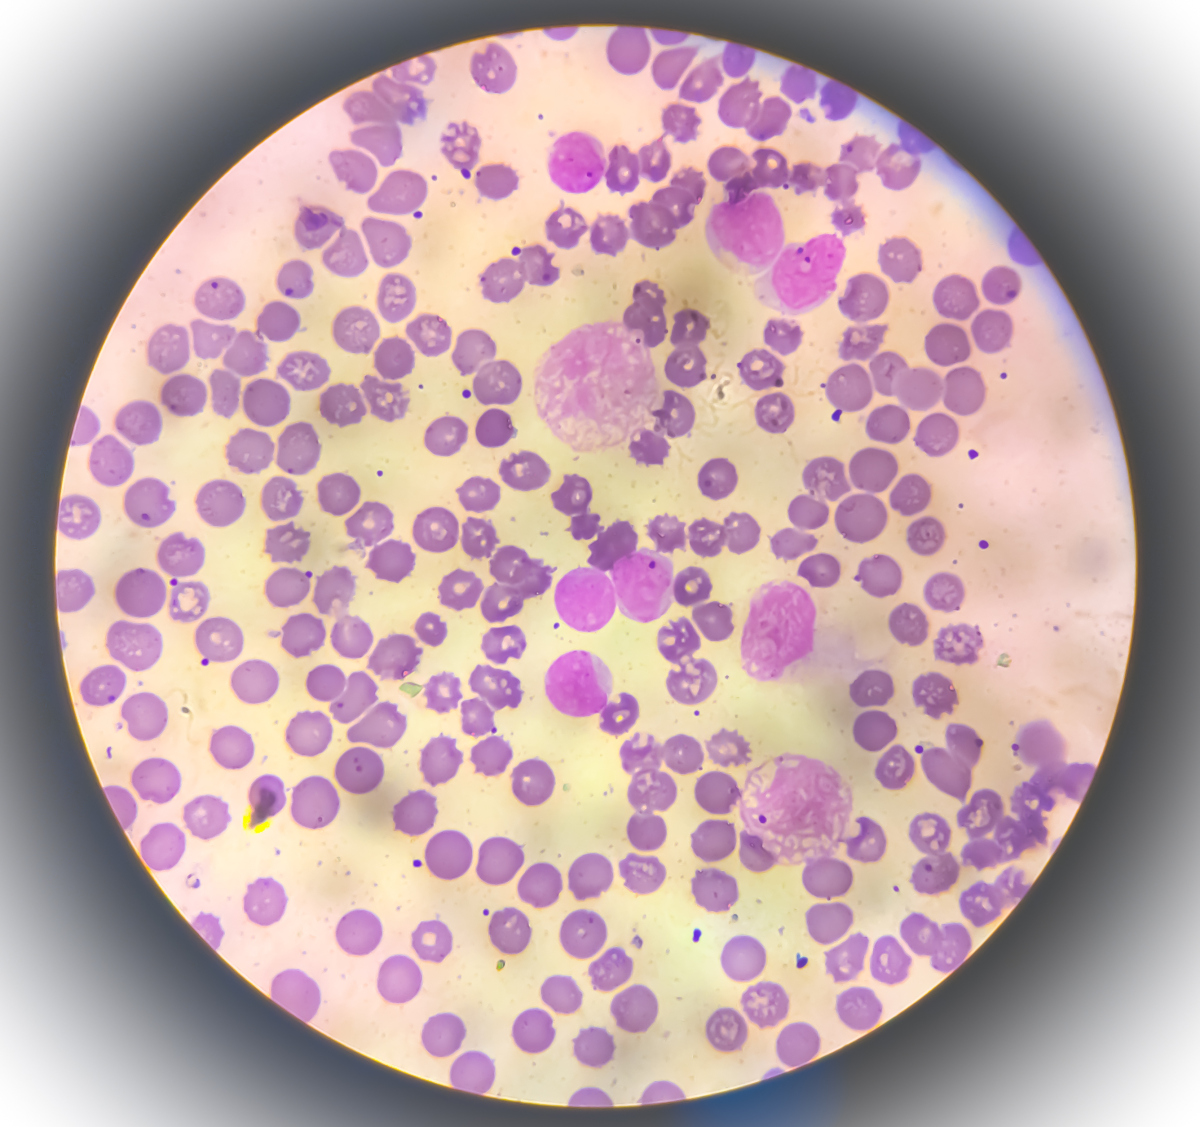
白血病,听起来就让人心生恐惧的疾病,究竟能活多久?

维甲酸 白血病

这种白血病被成功被治愈,现在药物只要300元,还被纳入国家医保
图片尺寸384x230
白血病晚期症状及预防措施💉
图片尺寸1200x1569
砒霜联合维a酸治疗白血病成功,汪女士重获新生 武汉市普仁医院血液
图片尺寸690x1211
白血病的早期症状有哪些
图片尺寸1133x1511
白血病,听起来就让人心生恐惧的疾病,究竟能活多久?
图片尺寸1200x1127
白血病是一种血液系统的恶性疾病,很多人听到这个词会
图片尺寸1862x2490
白血病,作为一种血液系统的恶性肿瘤,常常让人们对它
图片尺寸900x1200
白血病移植后,嘴巴一直排异没口水,太难了
图片尺寸843x1498
白血病要做什么检查?快来了解一下
图片尺寸1242x1660
他击败最凶险的白血病,却放弃专利让百万患者吃上13元的救命药
图片尺寸600x592 图片尺寸1080x1920
图片尺寸1080x1920 图片尺寸1080x1442
图片尺寸1080x1442
白血病药品
图片尺寸1200x960
皮肤瘀斑 牙龈出血?小心急性白血病找上门!
图片尺寸1200x1600
急性白血病治愈可能性,关键看这4点 分型决定
图片尺寸1862x2490
白血病主要是因为骨髓里的造血细胞发生了基因
图片尺寸750x1000
是恶性血液病,但随着治疗进步,规范治疗后
图片尺寸1242x1660
普纳替尼
图片尺寸1200x960
联合阿扎胞苷治疗idh1突变急性髓系白血病
图片尺寸560x560
白血病化疗副作用影响生活质量,通过针对性措施可有效缓解,帮助平稳
图片尺寸1242x1660









 图片尺寸1080x1920
图片尺寸1080x1920 图片尺寸1080x1442
图片尺寸1080x1442

图片尺寸1080x1920
图片尺寸1080x1920 图片尺寸1080x1442
图片尺寸1080x1442






